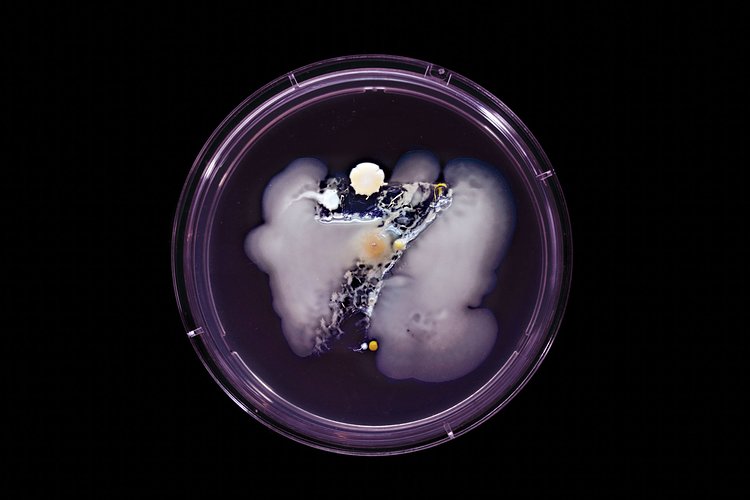
7 Train: Contains Staphylococcus aureus, Micrococcus luteus
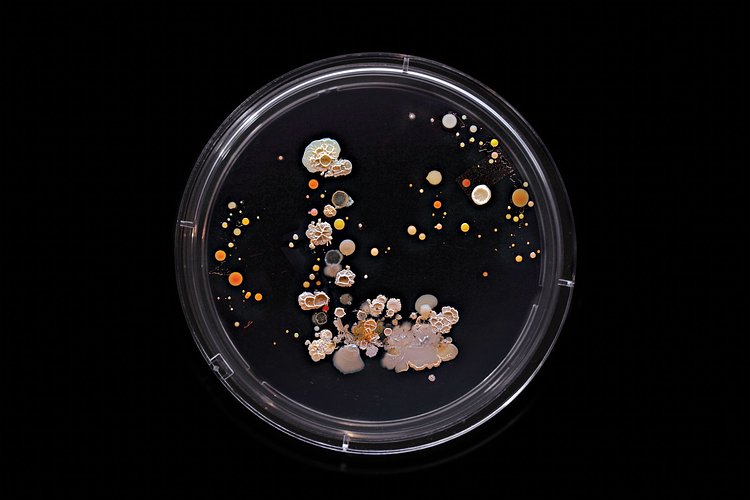
L Train: Contains E. coli, Proteus mirabilis, Micrococcus luteus, Bacillus subtilis, Serratia marcescens
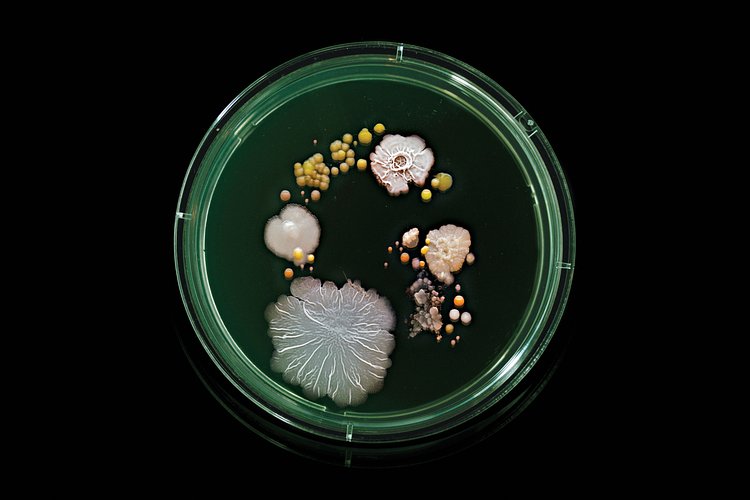
G Train: Contains E. coli, salmonella, Micrococcus luteus, Bacillus subtilis
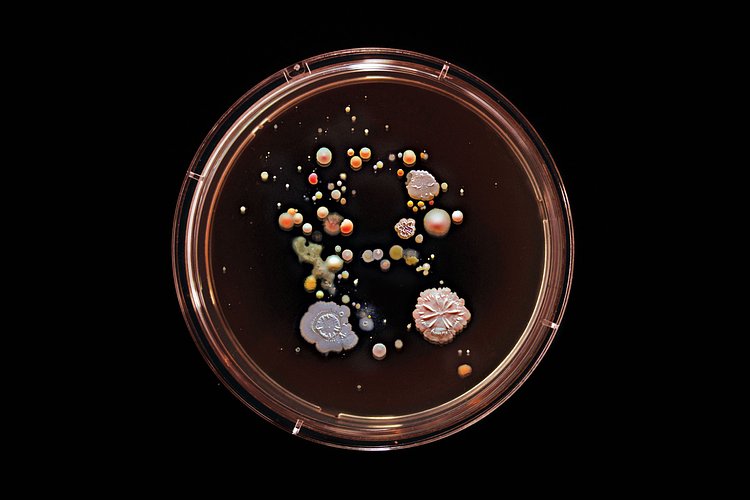
B Train: Contains E. coli, Staphylococcus aureus, Bacillus subtilis
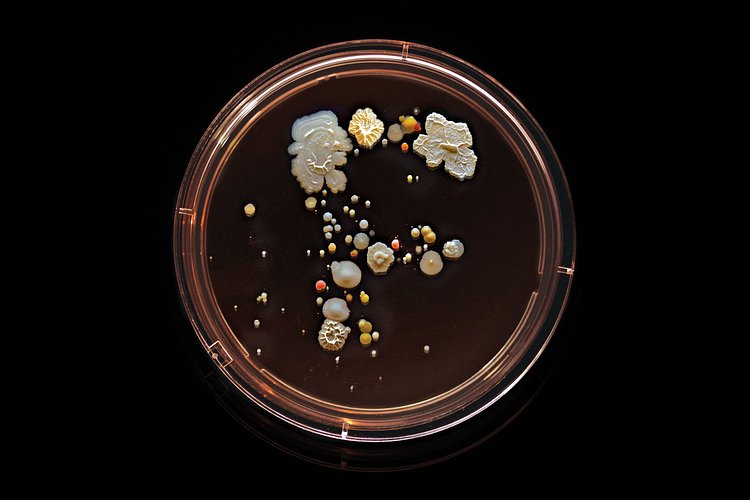
F Train: Contains E. coli, Micrococcus luteus, Bacillus subtilis

New York based photographer Craig Ward was riding the subway last year when he recalled the old urban myth of how touching the pole was like "shaking hands with 100 people all at once." Combining that thought with seeing a fellow photographer's bacteria photos, Ward came up with the idea for a series of photographs featuring the bacteria found on the subway.
The railings (unsurprisingly) yielded the most dramatic results. Not every colony can be named, but Ward was able to ID quite a few microorganisms by shape and color. Many are the benign everyday bacteria found in saliva and sweat and skin. Others are more sinister — Ward found E. coli and a few strains of staphylococcus, plus (inevitably) a bunch of mold. Some viewers “might just recoil and say it’s gross,” admits Ward. “But this is a portrait of New York. That day, that time.”
Read the full article in New York Magazine for more on the series.

via NY Mag
Something wrong with this post? Let us know!



